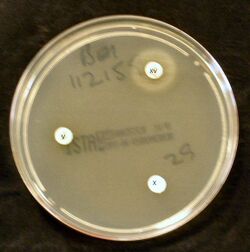

المستدمية النزلية
| المستدمية النزلية | |
|---|---|

| |
| H. influenzae on a chocolate agar plate | |
| التصنيف العلمي | |
| أصنوفة غير معروفة (أصلحها): | Haemophilus |
| Species: | Template:Taxonomy/HaemophilusH. influenzae
|
| Binomial name | |
| Template:Taxonomy/HaemophilusHaemophilus influenzae (Lehmann & Neumann 1896)
Winslow et al. 1917 | |
المستدمية النزلية أو المستدميات النزلية نمط B (بالإنگليزية: HAEMOPILUS INFLUENZA TYPE B) هي بكتيريا تسبب عدوى شديدة لدى الأطفال حديثي الولادة، والأطفال دون عمر الخمس سنوات.
التأريخ
وصفت المستدميات النزلية أول مرة من قبل بفايفر Pfeiffer عام 1892 حيث لاحظ وجود جراثيم في قشع المرضى أثناء إحدى جائحات الإنفلونزا الكبيرة، وافترض وجود علاقة سببية بين هذه الجراثيم والمتلازمة السريرية المعروفة بالأنفلونزا. وفي عام 1920 أعطيت هذه الجراثيم اسم المستدميات Haemophilus من قبل ونيسلو Einslow ورفاقه، وفي عام 1933 أوضح سميث Smith ورفاقه أن الأنفلونزا تنجم عن ڤيروس وأن المستدميات النزلية كانت سبباً لخمج ثانوي.
وفي الثلاثينيات من القرن العشرين أظهرت مارغريت بيتمان أنه يمكن عزل المستدميات النزلية إلى أشكال ذات محفظة وأشكال ليس لها محفظة، وقد حددت وجود ستة أنماط محفظية (f - a) ولاحظت أن كل الأشكال المعزولة من الدم والسائل الدماغي الشوكي كانت فعلياً من النمط المحفظي.
لقد كانت المستدميات النزلية النمط Hib) b) قبل إدخال اللقاحات الفعالة السبب الرئيس لالتهاب السحايا الجرثومي، وباقي الأمراض الجرثومية الغازية عند الأطفال دون عمر 5 سنوات. وكانت كل أخماج Hib الخطيرة تقريباً بين الأطفال دون عمر 5 سنوات، ويطور طفل من كل 200 طفل تقريباً مرضاً غازياً بالمستدميات النزلية b قبل عمر 5 سنوات. وإن ثلثي الحالات كانت عند الأطفال دون عمر 18 شهراً.
المستدميات النزلية
المستدميات النزلية عصورات Coccobacillus سلبية الغرام، وهي جراثیم هوائية عادة ولكن يمكن أن تكون لا هوائية مخيرة. ويحتاج نمو المستدميات النزلية في الزجاج إلى وجود عوامل نمو إضافية تشمل العامل Hemin) X) والعامل v (النيكوتيناميد أدنين دي نوكليوتيد (NAB)).
ويستخدم أغار Agar الشوكولا لعزل هذه الجراثيم، حيث لا تنمو بشكل عام المستدميات النزلية على أغار الدم الذي يفتقد إلى NAD.
تتكون الطبقة الخارجية من المستدميات النزلية من البولي ريبوزیل - ريبيتول فوسفات (PRP) Polyribosyl - ribitol - Phosphate وهو عدد سكاريد مسؤول عن الفوعة Virulence والمناعة وقد تمييز ستة أنماط من عديد السكاريد المحفظي متميزة عن بعضها من الناحية المستضدية والكيماوية الحيوية. ويرمز لها بالأنماط من a إلى v. وكانت المستدميات النزلية النمط 6 في عصر قبل اللقاحات تشكل 95٪ من الذراري المسببة للمرض الغازي.
الإمراض
تدخل المستدميات النزلية إلى الجسم عن طريق البلعوم الأنفي، حيث تستعمر البلعوم الأنفي وقد تبقى هناك بشكل عابر أو لعدة أشهر دون أن تسبب أي أعراض (الحامل اللاعرضي).
وفي عصر ما قبل التلقيح كانت المستدميات النزلية تعزل من البلعوم الأنفي عند 30.5٪ من الرضع والأطفال الطبيعيين وبشكل نادر عند البالغين. كذلك فإن الذراري غير المنوطة (ليس لها محفظة) توجد بشكل شائع في السبيل التنفسي عند الإنسان وهي ليست غازية عموماً.
إن الطريقة الدقيقة لغزو المجرى الدموي غير معروفة، وقد يكون الخمج التنفسي العلوي الڤيروسي أو بالميكوبلازما السابق عاملاً مساعداً.
تنتشر المستدميات النزلية في المجرى الدموي إلى أماكن بعيدة في الجسم، وتصاب السحايا بشكل خاص.
إن المظهر المميز لداء Hib هو الاستعداد للإصابة المعتمد على العمر. حيث تزود المناعة المنفعلة بعض الرضع بالوقاية من الإصابة خلال الشهور الستة الأولى من العمر وهذه الوقاية المنفعلة هي أضداد والدية من نوع IgG تنتقل عبر المشيمة أو عن طريق الإرضاع الوالدي. وتحدث ذروة معدلات الإصابة بعمر 6-7 شهور ثم تنخفض بعد ذلك. إن الإصابة الناجمة عن Hib لیست شائعة بعد عمر 5 سنوات. إن السبب المفترض لهذا النمط من توزع الإصابة المعتمد على العمر هو اكتساب المناعة الخلطية ضد Hib مع تقدم العمر.
إن الأضداد الموجهة ضد عديدات السكاريد المحفظية لجراثيم Hib وافية ومن غير المعروف مستوى الأضداد الدقيق اللازم للوقاية من المرض الغازي، ولكن يرتبط عيار الأضداد 1 مكروغرام/مل بعد 3 أسابيع من التلقيح مع الوقاية في الدراسات التي أجريت بعد التلقيح بلقاح PRP غير المقترن. ويقترح وجود وقاية طويلة الأمد ضد المرض الغازي. إن اكتساب الأضداد المحفظية والأضداد القاتلة للجرثوم يرتبط عكسياً مع نسبة الحدوث النوعية للعمر.
إن معظم الأطفال في عصر ما قبل اللقاح اكتسبوا مناعة طبيعية ضدHib بعمر 5-6 سنوات عن طريق الخمج اللاعرضي بالمستدميات النزلية، ولكن لما كانت نسبة صغيرة نسبياً من الأطفال يحملون Hib في البلعوم الأنفي في أي وقت، فقد تم الافتراض أن التعرض للجراثيم التي تتشارك مع المستدميات النزلية ببنيات مستضدية مشتركة (ندعوها الجراثيم ذات الارتكاس المتصالب) قد يعرض أيضا تطور الأضداد المحفظية للمستديمات النزلية. إن التعرض الطبيعي لجراثيم Hib يعرض أيضاً الأضداد ضد البروتينات وعديدات السكاريد الشحمية وباقي المستضدات الموجودة في الغشاء الخارجي للجرثوم.
قد يكون التكوين الوراثي للثوي عاملاً هاماً في تحديد القابلية للإصابة بخمجHib . وقد ارتبط خطر الإصابة بخمجHib مع عدد من الواصمات المورثية لكن آلية هذه الترافقات غير معروفة. ولم يتم حتى الآن إظهار علاقة مورثية وحيدة تنظم الاستعداد للإصابة أو الاستجابات المناعية المستضدات عديد السكاريد .
المظاهر السريرية
قد يصيب المرض الغازي الناجم عن المستدميات النزلية 6 العديد من الأعضاء. وأشيع أنماط المرض الغازي هو التهاب السحايا والتهاب لسان المزمار وذات الرئة والتهاب المفاصل والتهاب النسيج الخلوي.
• التهاب السحايا: هو التهاب الأغشية التي تغطي الدماغ، ويعتبر أشيع التظاهرات السريرية لمرض Hib الغازي ويشكل 50-65% في عصر ما قبل اللقاح. تشمل المظاهر الرئيسية لالتهاب السحايا، الحمى، وتدني الحالة العقلية، وصلابة العنق. وتبلغ نسبة الوفيات 2-5% رغم المعالجة المناسبة بالصادات وتحدث العقابيل العصبية في 15-30٪ من الناجين.
•التهاب لسان المزمار: وهو حالة إسعافية مهددة للحياة قد تسبب الانسداد التنفسي.
• التهاب المفاصل الإنتاني.
• التهاب النسيخ الخلوي: وهو خمج جلدي سريع التطور، يشمل عادة الوجه أو الرأس أو العنق.
• ذات الرئة: قد تكون بؤرية خفيفة أو تتطور إلى تقيح الجنب الشديد.
• ذات العظم والنقي.
• التهاب التامور.
إن التهاب الأذن الوسطى، والتهاب القصبات الحاد الناجمين عن المستدميات النزلية ينجمان عادة عن الذراري غير المنمطة وتشكل %10-5 فقط من المستدميات النزلية المسببة لالتهاب الأذن الوسطى.
التشخيص


1. تلوين غرام: إن تلوين غرام لسوائل الجسم المخموجة قد يظهر وجود عصورات صغيرة سلبية الغرام مما يقترح وجود إصابة غازية بالمستدميات. ويجب زرع السائل الدماغي الشوكي والدم وسائل الجنب والسائل المفصلي والرشافة المأخوذة من الأذن الوسطى على أوساط زرع مناسبة. ويعتبر الزرع الإيجابي للمستدميات النزلية مؤكداً للتشخيص.
2. يجب إجراء التميط المصلي لكل المستدميات النزلية المعزولة وهذا الأمر هام جدا، خاصة عند الأطفال دون عمر 15 سنة حيث يحدد هذا الاختبار إن كانت المستدميات النزلية المعزولة من النمط 6 أم لا حيث إن النمط b فقط هو الذي يمكن الوقاية منه باللقاح.
3.تحري المستضد: ويستخدم كوسيلة مساعدة للزرع خاصة عند المرضى الذين عولجوا جزئياً
بالصادات. وبالتالي قد لا تكون الجراثيم عيوشة بالزرع. ويتوفر نمطان لهذا الاختبار:
• التراص باللاتكس: وهو طريقة سريعة وحساسة ونوعية تستخدم لتحري مستضد عديد السكاريد المحفظي لجراثيم [CSF 9 Hib، لكن الفحص السلبي لا ينفي التشخيص وقد ذكرت نتائج إيجابية كاذبة. ولا يوصى بتحري المستضد في البول أو المصل.
• الرحلان المناعي الكهربي المعاكس للتيار Counterimmunoelectro (CIE) ، وهو أقل حساسية من سابقه ويستغرق وقتاً أطول ومن الصعب أجراؤه.
التدبير الطبي
يجب بصورة عامة قبول كل الحالات المصابة في المشفى والبدء مباشرة بالمعالجة بالكلورامفينكول مع الأمبيسلين أو أحد سيفالوسبورينات الجيل الثالث (السيفوتاكسيم أو السفتریاکسون). يستمر شوط المعالجة 10 أيام عادة. وقد أصبحت الذراري المقاومة للأمبسيلين شائعة في الولايات المتحدة ويجب الا يعطى لوحده كمعالجة تجريبية في الالتهابات المهددة للحياة.
الوبائيات
- الحدوث: يحدث مرض Hib في كل أنحاء العالم.
- المستودع: يعتبر الإنسان (الحملة اللاعرضيون) المستودع الوحيد المعروف ولا تعيش Hib في البيئة على السطوح غير الحية.
- الانتقال: إن طريق الانتقال الرئيسي هو القطيرات التنفسية رغم أن الدليل المؤكد على هذا الأمر غير
موجود.
- النمط الفصلي: أظهرت عدت دراسات في عصر ما قبل اللقاح وجود نمط فصلي ثنائي الطور في الولايات المتحدة حيث تحدث ذروة بين أيلول وكانون الأول وذورة ثانية بين آذار وآيار. ومن غير المعروف سبب هذا النمط ثنائي الطور.
- السراية: إن إمكانية انتقال داء Hib الغازي تعتبر محدودة نسبياً ما عدا في حالات معينة خاصة الأشخاص المخالطين بشكل مباشر للمريض (مثل أفراد العائلة) حيث قد يؤدي في هذه الحالة إلى حدوث أوبئة أو انتقال ثانوي مباشر للمرض.
الاتجاهات العامة في الولايات المتحدة
قدر في أوائل الثمانينيات حدوث حوالي 20 ألف حالة سنوياً في الولايات المتحدة خاصة بين الأطفال دون عمر 5 سنوات (5040 حالة / 100 ألف من السكان)، وقد هبطت نسبة حدوث مرض Hib الغازي بشكل دراماتيكي في أواخر الثمانينيات ويتوافق ذلك مع الترخيص باستخدام لقاح Hib المقترن، وقد انخفضت نسبة الحدوث أكثر من 99 ٪ مقارنة مع عصر ما قبل اللقاح.
وقد تم تسجيل حدوث حوالي 1247 حالة وسطية في السنة بين عامي 1996-2000 ولهذا السبب تنقص فرصة تعرض الأطفال غير الملقحين للمرض.
إن نسبة الحدوث مرتبطة بشكل وثيق مع العمر، ففي عصر ما قبل اللقاح حدث 60٪ من المرض الغازي دون عمر 12 شهراً مع ذروة حدوث بين عمر 6-11 شهراً، وشكل الأطفال الأكبر من 5 سنوات أقل من 10% من حالات المرض الغازي.
وبين عامي 1998 و2000 كان 44٪ من الأطفال الأقل من عمر 5 سنوات المصابين بالمرض الغازي دون عمر 6 شهور (لم يكملوا سلسلة التلقيح الأولية) و56 ٪ أكبر من عمر 6 شهور (ومن هؤلاء 68 ٪ لم يكملوا سلسلة التلقيح أو أن حالتهم التمنيعية غير معروفة).
إن 32 % من الأطفال (6-59شهراً) المصابين بالمرض الغازي Hib تلقوا 3 جرعات أو اكثر من لقاح المستدمية النزلية B، ومنهم 22% تلقوا جرعة داعمة قبل 14 يوماً أو أكثر من بداية المرض. وإن سبب فشل اللقاح عند هؤلاء الأطفال غير معروف.
عوامل الخطورة للإصابة بمرض Hib
- عوامل خاصة بالثوي:
1. العرق:(زيادة خطر الإصابة عند السود والأمريكيين الأصليين وذوي الأصول الأسبانية) وقد يكون سبب ذلك الاختلافات الاجتماعية والاقتصادية التي تترافق مع كل من داء Hib والعرق.
2. الأمراض المزمنة:(مثل فقر الدم المنجلي، متلازمات عوز الأضداد، الخباثات خاصة اثناء المعالجة الكيماوية).
3. الجنس: وهو عامل محتمل إصابة الذكور أكثر من إصابة الإناث.
- عوامل التعرض:(عوامل خاصة بمحيط الشخص):
1. الازدحام في المنزل.
2. عدد أفراد المنزل الكبير.
3 . وجود الطفل في مراكز الرعاية اليومية.
4. الحالة الاجتماعية الاقتصادية المنخفضة.
5. مستوى تعليم الوالدين المنخفض.
6. وجود أخوة بسن المدرسة.
- العوامل الواقية من المرض: (تنحصر فعاليتها عند الرضع دون عمر 6 أشهر)
1. الإرضاع الوالدي.
2. الأضداد المنفعلة المكتسبة عن طريق المشيمة.
مرض Hib الثانوي
يعرف مرض Hib الثانوي بأنه المرض الذي يحدث خلال 1-60 يوماً من التماس مع الطفل المريض، ويشكل مرض Hib الثانوي أقل من 5 ٪ من حالات مرض Hib الغازي. وقد وجدت ست دراسات عند المخالطين في المنزل أن معدل الإصابة الثانوية كان 0.3 % خلال الشهر التالي لبداية المرض عند الحالة الأولى Index case وهذا المعدل يعادل 600 ضعف خطر الإصابة عند عامة السكان. ويختلف معدل الإصابة حسب العمر حيث تبلغ 3.7% بين الأطفال دون عمر السنتين في حين تكون 0٪ عند الأطفال المخالطين فوق عمر 6 سنوات، وقد حدث 64% من الحالات الثانوية بين المخالطين في المنزل خلال الأسبوع الأول باستثاء الساعات الأربع والعشرين الأولى من بداية المرض عند الحالة الأولى وحدثت 20% من الحالات خلال الأسبوع الثاني و 16% خلال الأسبوعين الثالث والرابع.
أما بالنسبة للانتقال الثانوي للمرض في دور الرعاية اليومية، فهناك معلومات متناقضة حول هذا الأمر ويتراوح معدل الإصابات الثانوية بين 0%و 2.7% ويبدو أن معظم الدراسات تقترح أن المخالطين في دور الرعاية اليومية معرضون لخطورة قليلة نسبية للانتقال الثانوي لمرضHib.
لقاح المستدميات المنزلية النمط B
- الخصائص:
تم التصريح عام 1985 في ]]الولايات المتحدة[[ باستخدام لقاح عديد السكاريد النقي (HbPV) Pure polysaccharide vaccine، ولم يكن هذا اللقاح فعالاً عند الأطفال دون عمر 18 شهراً، كما أن تقديرات فعاليته عند الأطفال الأكبر تراوحت بين 88% و 69% (تشير الفعالية السلبية إلى أن خطر الإصابة بالمرض أكبر عند الأشخاص الملقحین مقارنة مع غير الملقحين). استخدم لقاح HbPV حتى عام 1988 ثم توقف استخدامه في الولايات المتحدة.
إن خصائص لقاح عدد سكاريد Hib مشابهة لخصائص باقي اللقاحات عديدة السكارید (مثل لقاح الرئويات ولقاح السحائيات)، كانت الاستجابة للقاح بشكل وصفي مستقلة عن الخلية التالية كما أنها معتمدة على العمر وكانت القدرة الاستمناعية Immunogenicity ضعيفة عند الأطفال دون عمر السنتين، إضافة لذلك لم يلاحظ أي تعزيز في مستوى الأضداد مع إعطاء الجرعات المتكررة كما أن الأضداد الناجمة كانت من نوع IgM قليل الألفة Low - affinity نسبياً وكان التحول إلى إنتاج IgG ضعيفاً.
لقاحات المستدمية النزلية b المقترنة (عديد السكاريد - البروتين)
الاقتران Conjugation هو عملية ارتباط کيماوي بين عديد السكارید (وهو مستضد ضعيف) من البروتين (الحامل Carrier) وهو مستضد أكثر فعالية.
تؤدي هذه العملية إلى تغيير عديد السكاريد من مستضد مستقل عن الخلية التائية إلى مستضد معتمد على الخلية التائية وتحسن القدرة الاستمناعية بشكل كبير خاصة عند الأطفال الصغار، كما أن الجرعات المتكررة من لقاحات Hib المقترنة تؤدي إلى تعزيز مستوى الأضداد وتسمح بنضج المناعة النوعية للصنف Class - specific immunity مع سيطرة أضداد IGg، كما تؤدي اللقاحات المقترنة إلى تحريض استجابة مناعية للبروتين الحامل (المفيد) وتشكل أضداد له.
إن أول لقاح من لقاحات Hib المقترنة هو (ProHIBIT و PRP - D) وقد تم الترخيص باستخدامه في كانون الثاني 1987 في الولايات المتحدة، ولم يكن هذا النوع ممنعاً بشكل ثابت عند الأطفال دون عمر 18 شهر ولم يوص باستخدامه عند الرضع.
وتم السماح باستخدام ثلاثة أنواع أخرى من لقاحات Hib عند الرضع الصغار منذ عمر 6 أسابيع، كذلك يتوفر أيضا لقاحان آخران مشتركان يحتويان لقاح Hib المقترن.
فعالية اللقاح وقدرته الاستمناعية
إن لقاحات Hib المقترنة الثلاثة المصرح باستخدامها عند الرضع مستمنعة (مولدة للمناعة) بشكل كبير وإن أكثر من 95% من الرضع سوف يتطور لديهم مستويات وافية من الأضداد بعد 2-3 جرعات من اللقاح. وقد قدرت الفعالية السريرية بحدود 95-100٪ ومن النادر جداً حدوث داء Hib الغازي عند رضيع تم تلقيحه بشكل كامل.
إن لقاح Hib مستمنع Immunogenic عند المرضى المعرضين لخطورة حدوث المرض الغازي مثل المرضى المصابين بداء الخلية المنجلية، والابيضاض، وخمج ڤيروس عوز المناعة البشري HIV، والمرضى الذين أجري لهم استئصال الطحال، ولكن تختلف القدرة الاستمناعية عند المرضى المصابين بخمج HIV حسب مرحلة الخمج ودرجة التثبيط المناعي.
جدول التلقيح
يجب أن يعطي كل الرضع بما فيهم أولئك الذين ولدوا خدجاً سلسلة بدئية من لقاح Hib المقترن (المفرد أو المشترك) تبدأ بعمر الشهرين. ويعتمد عدد الجرعات في السلسلة البدئية على نمط اللقاح المستخدم. تتكون السلسلة البدئية من جرعتين إذا استخدم لقاح Pedvax) PRP - OMP IIIB)، أما إذا استخدم لقاح HibTiTER) HbOC) أو لقاح ActHIB) PRP - T) فنحتاج إلى 3 جرعات. ويوصي بجرعة داعمة بعمر 12-15 شهراً بغض النظر عن اللقاح الذي استخدم في السلسلة البدئية.
إن الفترة المثالية التي تفصل بين الجرعات شهران، والحد الأدنى لهذه الفترة الفاصلة 4 أسابيع. ويجب أن تفصل الجرعة الداعمة عن الجرعة التي قبلها (الجرعة الثانية أو الثالثة) فترة 8 أسابيع على الأقل. يمكن إعطاء لقاحات Hib بنفس الوقت مع باقي اللقاحات.
لقد أشارت المعلومات الحديثة إلى أن إعطاء لقاحات Hib المقترنة قبل عمر 6 أسابيع قد يحرض حدوث التحمل المناعي Immunologic Tolerance للجرعات اللاحقة من لقاح Hib. أي تعمل الجرعة التي تعطى قبل عمر 6 أسابيع على جعل الطفل غير قادر على الاستجابة للجرعات اللاحقة من لقاح Hib، وبالنتيجة يجب عدم إعطاء لقاحات Hib بما فيها اللقاحات المشتركة التي تحوي لقاح Hib المقترن أبداً إلى الطفل دون عمر 6 أسابيع.
إن لقاحات Hib الثلاثة المصرح باستخدامها عند الرضع يمكن المبادلة بينها، وإن سلسلة التلقيح التي يستخدم فيها أكثر من نوع من أنواع لقاحات Hib سوف تحرض حدوث مستويات واقية من الأضداد.
وإذا كان من الضروري تغيير نمط اللقاح، فإن أي سلسلة بدئية مكونة من 3 جرعات من أي لقاح من لقاحات Hib تعتبر سلسلة كاملة. يمكن استخدام أي من لقاحات Hib المقترنة المصرح باستخدامها لإعطاء الجرعة الداعمة بغض النظر عن اللقاح او اللقاحات التي استخدمت في سلسلة التلقيح البدئية.
قد لا يحتاج الأطفال بعمر 7 شهور أو أكثر السلسلة الكاملة للتلقيح (3 أو 4 جرعات) ويعتمد عدد جرعات لقاح Hib اللازمة لإكمال سلسلة التلقيح على عمر الطفل الحالي.
- HiBTITER,ACTHIB:
إن الرضع غير الملقحين سابقاً الذين تتراوح أعمارهم بين 2-6 شهور، يجب أن يعطوا ثلاث جرعات من هذا اللقاح بفاصل شهرين. يليها جرعة داعمة بعمر 12-15 شهراً (بعد شهرين على الأقل من آخر جرعة). أما الأطفال غير الملقحين الذين تتراوح أعمارهم بين 7-11 شهراً فيعطون جرعتين من اللقاح بفاصل شهرين ويليهما جرعة داعمة بعمر 12-15 شهراً (بفاصل شهرين على الأقل عن آخر جرعة).
ويعطى الأطفال بعمر 12-14 شهراً غير الملقحين سابقاً جرعتين من اللقاح بفاصل شهرين على الأقل (إحداهما هي جرعة داعمة). أما الطفل غير الملقح سابقاً الذي يتراوح عمره بين 15-59 شهراً فيعطى جرعة وحيدة من اللقاح.
- Pedvax HIB:
إن الرضع بعمر 11-2 شهراً غير الملقحين سابقاً يعطون جرعتين من هذا اللقاح بفاصل شهرين يليهما جرعة داعمة بعمر 12-15 شهراً (بعد شهرين على الأقل من آخر جرعة)، أما الأطفال بعمر 14-12 شهراً غير الملقحين سابقاً فيجب إعطاؤهم جرعتين من اللقاح بفاصل شهرين. وأي طفل بعمر 15-59 شهراً ولم يتم تلقيحه سابقاً يجب أن يعطى جرعة وحيدة من اللقاح.
*PRP- D:
يمكن إعطاء جرعة وحيدة من هذا اللقاح إلى الأطفال بعمر 15-59 شهراً غير الملقحين سابقاً ويمكن أن يستخدم هذا اللقاح كجرعة داعمة بعمر 12-18 شهراً بعد إعطاء 2 أو 3 جرعات من سلسلة التلقيح البدئية بغض النظر عن نوع اللقاح المستخدم في السلسلة البدئية. لم يصرح باستخدام هذا اللقاح عند الرضع بسبب قدرته المحدودة على توليد المناعة واختلاف فعالیته الواقية عند هذه المجموعة العمرية.
عدم إكمال سلسلة التلقيح بلقاح Hib
قد لا يكمل بعض الأطفال سلسلة التلقيح بلقاح Hib أي يعطون جرعة أو أكثر من جرعات لقاح Hib ولا يكملون باقي الجرعات، وهؤلاء الأطفال قد لا يحتاجون إلى كل جرعات اللقاح الباقية التي لم يستكملوها.
لا يؤدي المرض الغازي بالمستدميات النزلية دوماً إلى تطور مستويات واقية من الأضداد الموجهة ضد PRP ولذلك فإن الأطفال دون عمر السنتين الذين يصابون بمرض Hib الغازي بجب اعتبارهم غير ممنعين ضد Hib، وبالتالي يجب أن يعطوا لقاح Hib حسب البرنامج الموصى به. ويجب أن يتم تلقيح هؤلاء الأطفال بأسرع وقت ممكن خلال النقاهة من المرض ثم يكمل برنامج التلقيح حسب عمر الطفل.
تلقيح الأطفال الكبار والبالغين
بصورة عامة لا يحتاج الأطفال الأكبر من 59 شهراً إلى التلقيح ضد Hib، وإن غالبية هؤلاء الأطفال ممنعون ضد Hib بسبب الخمج اللاعرضي في فترة الرضاعة على الأرجح. ولكن بعض الأطفال الكبار والبالغين لديهم عوامل خطورة تزيد احتمال إصابتهم بمرض Hib الغازي وهؤلاء يمكن أن يتم تلقيحهم وتشمل عوامل الخطورة:
• الأشخاص المصابين باللاطحالية Asplenia التشريحية أو الوظيفية (مثل داء الخلية المنجلية أو استئصال الطحال الجراحي).
• العوز المناعي (خاصة الأشخاص المصابين بعوز IgG).
• التثبيط المناعي الناجم عن المعالجة الكيماوية للسرطان أو الخمج [[ڤيروس عوز المناعة البشري HIV|بڤيروس عوز المناعة البشري]].
إن الأشخاص غير الملقحين سابقاً الذين تتجاوز أعمارهم 59 شهراً ولديهم أحد عوامل الخطورة السابقة يجب إعطاؤهم جرعة أطفال واحدة على الأقل من أي من لقاحات Hib المقترنة المصرح باستخدامها.
اللقاحات المشتركة
يتوفر حالياً لقاحان مشتركان يحتويان على لقاح المستدميات النزلية النمط 6 في الولايات المتحدة وهما لقاح TriHIBit) DTaP - Hib، شركة Aventis Pasteur) ولقاح Hib - التهاب الكبد COMVAX) B، شركة Merck قسم اللقاحات). وإن اللقاحات المشتركة التي تحوي لقاح السعال الديكي كامل الخلية ولقاح Hib لم تعد متوفرة في الولايات المتحدة.
* TriHIBir:
تمت الموافقة على لقاح TriHIbit في الولايات المتحدة في سبتمبر 1996 وهو لقاح مشترك يتكون من لقاحين هما لقاح السعال الديكي اللاخلوي (Tripedia) ولقاح المستدميات النزلية (ActHIB) ويكون هذان اللقاحان منفصلين عن بعضهما (كل منهما في فلاكونة خاصة) وتستخدم مكونة DTaP لإعادة تشكيل مكونة Hib (أي يستخدم لقاح DTaP لحل لقاح Hib). وهما يسوقان معاً في علبة واحدة تحت اسم TriHIBit، ولا يمكن استخدام أشكال تجارية أخرى من لقاحي Hib وDTaP لإنتاج هذا اللقاح المشترك (مثلاً لا يستخدم Infanrix بدلاً عن Tripedia). ولكن من المقبول في حال عدم توفر هذا اللقاح المشترك (أي وجود اللقاحين ما في علبة واحدة) استخدام ActHIB وTripedia المنفصلين (أي وجود كل منهما في علبة منفصلة) لتشكيل هذا اللقاح المشترك وفي هذه الحالة يجب تسجيل رقم تشغيلة كل لقاح على سجل الطفل.
توجد دلائل على نقص القدرة الاستمناعية للقاح Hib عندما يستخدم على شكل لقاح مشترك، ولذلك فإن TriHIBit لم توافق عليه إدارة الغذاء والدواء الأمريكية FDA للاستخدام في السلسلة البدئية للتلقيح بعمر 2-4-6 شهور. في حين تمت الموافقة على استخدامه في الجرعة الرابعة من لقاح Hib ولقاح DTaP. وإذا أعطي TriHIBit في جرعة أو اكثر من السلسلة البدئية (بعمر 2 أو 4 أو 6 شهور) فإن جرعات Hib هذه يجب إهمالها ويعاد تلقيح الطفل مرة ثانية بلقاح Hib حسب عمره، في حين قد تعتبر جرعات DTaP مقبولة ولا حاجة لإعادتها.
يمكن استخدام لقاح TriHIBit كجرعة داعمة (نهائية بعد التلقيح بلقاح Hib وحيد المستضد أو المشترك (لقاح Hib - التهاب الكبد Comvax). ولهذا يمكن استخدام TriHIBIT إذا كان عمر الطفل أكبر من 12 شهراً واعطي على الأقل جرعة سابقة واحدة من لقاح Hib قبل أكثر من شهرين، وفي هذه الحالة يكون لقاح TriHIBit هو الجرعة الأخيرة من سسلسة لقاح Hib، على سبيل المثال يمكن استخدام TriHIBit للجرعة الداعمة بعمر 12-15 شهراً عند طفل اعطي لقاح Comvax أو PedvaxHib بعمر 2 و4 شهور أو اعطي جرعات سابقة من لقاح HibTiter أو 2 Act Hib. كذلك يمكن استخدام TrHIBit بعمر 15-59 شهراً عند الطفل الذي أعطي على الأقل جرعة سابقة من أي لقاح يحوي Hib، وإذا لم يعط الطفل أي جرعة سابقة من لقاح Hib فلا يجوز استخدام TriHIBit.
- لقاح COMVAX:
هو لقاح مشترك يتكون من لقاح التهاب الكبد B ولقاح Hib، وقد تمت الموافقة على استخدامه في تشرين الأول 1996. يحتوي هذا اللقاح على جرعة نظامية من PRP-OMP، و5 مكروغرام من لقاح التهاب الكبد لشركة ميرك (جرعة الأطفال). يعطى لقاح Comvax عندما يستطب إعطاء أي من المستضدين أو كليهما. يجب الانتباه إلى عدم إعطاء لقاح Hib إلى الرضع دون عمر 6 أسابيع بسبب إمكانية حدوث التحمل المناعي لمستضد Hib. ولذلك لا يعطى لقاح Comvax للرضع دون عمر 6 أسابيع (أي جرعة التهاب الكبد B عند الولادة أو الجرعة بعمر الشهر إذا كان الرضيع على برنامج الجرعات 0-1-6). كذلك لم يصرح باستخدام Comvax عند الرضع لأمهات إيجابيات العامل الأسترالي (أي الخمج الحاد أو المزمن بفيروس التهاب الكبد B).
الارتكاسات الجانبية التالية للتلقيح
إن الارتكاسات الجانبية التالية للقاحات Hib المقترنة غير شائعة وتشمل:
• الاحمرار والتورم والألم مكان الحقن وقد ذكر حدوثها عند 5-30 ٪ من الملقحين وتزول عادة خلال 12-24 ساعة.
• ارتكاسات جهازية (نادرة) مثل الحمى والهياج.
إن الارتكاسات الجانبية الناجمة عن إعطاء لقاح TriHIBit مشابهة للارتكاسات الناجمة عن إعطاء مكونات هذا اللقاح بشكل منفصل وهي ناجمة على الأرجح عن مكونة السعال الديكي في لقاح DTaP.
مضادات الاستطباب والتحذيرات
• الأشخاص الذين حدث لديهم ارتكاس تأقي تالٍ لجرعة سابقة من لقاح Hib.
• يجب تأخير اللقاح عند الأطفال المصابين بمرض حاد شديد أو متوسط الشدة أما الأمراض الخفيفة (مثل الخمج التنفسي العلوي الخفيف) فلا تعتبر مضاد استطباب للتلقيح.
• إن لقاحات Hib المقترنة مضاد استطباب عند الرضع دون عمر 6 أسابيع بسبب احتمال حدوث التحمل المناعي.
• أما بالنسبة للقاحي Comvax وTriHIBit (لقاحات Hib المشتركة فإن مضادات الاستطباب والمحاذير الخاصة بها هي نفسها مضادات استطباب ومحاذير اللقاحات المكونة لها (أي Hib - DTaP - التهاب الكبد B).
تخزين اللقاح والتعامل معه
يجب نقل كل لقاحات Hib المقترنة في أوعية معزولة تحافظ على البرودة. يمكن تخزين اللقاح حائل (الذي لا يحتاج إلى حله) بدرجة حرارة البراد (2-8 درجة مئوية) أو (35-46 فهرنهايت). يجب عدم تجميد لقاح Hib. إن لقاحات Hib تبقى ثابتة لمدة 30 يوماً بعد حلها إذا تم حفظ اللقاحات بدرجة حرارة البراد.
ان فلاكونات اللقاح الجماعية المهيأة لإعطاء جرعات متعددة يمكن استخدامها حتى ينتهي تأريخ صلاحيتها بشرط وقايتها من التلوث. أما بالنسبة للقاحي Act HIB وTriHIBit فيجب استخدامها خلال 24 ساعة من حل اللقاح.
الوقاية بالريفامبين
أظهرت دراسات عديدة أن الريفامبين قادر على استئصال حملة Hib في أكثر من 95% من المخالطين لحالات Hib البدئية بما فيهم الأطفال في دور الرعاية اليومية. ويجب تقييم المخالطين بسرعة إذا تطور لديهم أعراض تقترح الإصابة بداء Hib الغازي مثل الحمى أو الصداع.
لا تستطب الوقاية الكيماوية باستخدام الريفامبين عند المخالطين في المنزل إذا كان كل الأطفال المخالطين دون عمر 4 سنوات ممنعين بشكل كامل ضد Hib.
ويعتبر الطفل ممنعاً بشكل كامل ضد Hib إذا كان قد اعطي:
1. جرعة واحدة على الأقل من لقاح Hib المقترن بعمر 15 شهراً.
2. جرعتين من لقاح Hib المقترن بعمر 12-14 شهراً.
3. جرعتين أو أكثر من لقاح Hib المقترن بعمر دون 12 شهراً يليها جرعة داعمة بعمر 12 شهراً.
وإذا كان بين المخالطين واحد أو أكثر من الرضع دون عمر 12 شهراً (بغض النظر عن حالة التلقيح) أو وجد طفل بعمر 1-3 سنوات لم يلقح بشكل كامل فعندها يجب إعطاء الريفامبين إلى كل المخالطين في المنزل وقائياً عند حدوث إصابة غازية بالمستدميات النزلية عند أي من أفراد العائلة. وإذا كان جميع أفراد العائلة فوق عمر 4 سنوات فلا ضرورة للوقاية.
يعطى الريفامبين بجرعة وحيدة يومية تبلغ 20 ملغ/كغ (الجرعة القصوى 600 ملغ) لمدة 4 أيام، أما بالنسبة للرضع دون عمر الشهر (الولدان) فتكون الجرعة 10 ملغ/كغ مرة واحدة يومياً لمدة 4 أيام.
أما بالنسبة لاستخدام الريفامبين في مراكز الرعاية اليومية، فما زال موضوعاً مثيراً للجدل. ولكن رغم أن المعلومات حول خطر الإصابة غير كاملة، فإنه يجب إعطاء الريفامبين إلى كل الطلاب وطاقم الصف بغض النظر عن العمر حسب الجرعات المبينة سابقاً. وليس من الضروري استخدام الوقاية بالريفامبين إذا كان كل الأطفال دون عمر 4 سنوات قد أكملوا تمنيعهم. يعتبر الريفامبين مضاد استطباب عند النساء الحوامل؛ لأن تأثيراته على الجنين غير معروفة تماماً إضافة إلى كونه مشوهة عند حيوانات المخبر.
يجب البدء بالوقاية بالريفامبين بأسرع وقت ممكن، وإذا انقضى أكثر من 14 يوماً منذ التماس الأخير مع الحالة الدالة (المريض) Index case، فإن فائدة الوقاية بالريفامبين قد تنخفض. ولابد من إعطاء الريفامبين قبل التخريج من المشفى للطفل المصاب بداء Hib الغازي لأن الصادات المستخدمة للعلاج لا تستاصل حالة الحملة بشكل موثوق.
تحدث التأثيرات الجانبية للريفامبين عند 20% من الحالات وتشمل الغثيان والإقياء والإسهال والصداع والدوار، كما ينتشر الريفامبين في سوائل الجسم بشكل جيد مسببة تلون البول باللون البرتقالي وقد يسبب تلون العدسات اللاصقة اللينة والقرنية المزورعة إضافة إلى تأثيره في استقلاب عدد من الأدوية مثل مانعات الحمل الفموية (ينقص فعاليتها) والستيروئيدات والأدوية الخافضة للسكر الفموية.
المصادر
- [1].
- ^ د. عماد محمد زوكار، د. أحمد محمد نوح: الرجع الشامل في اللقاحات، دار علوم القدس، الطبعة الأولى 2005